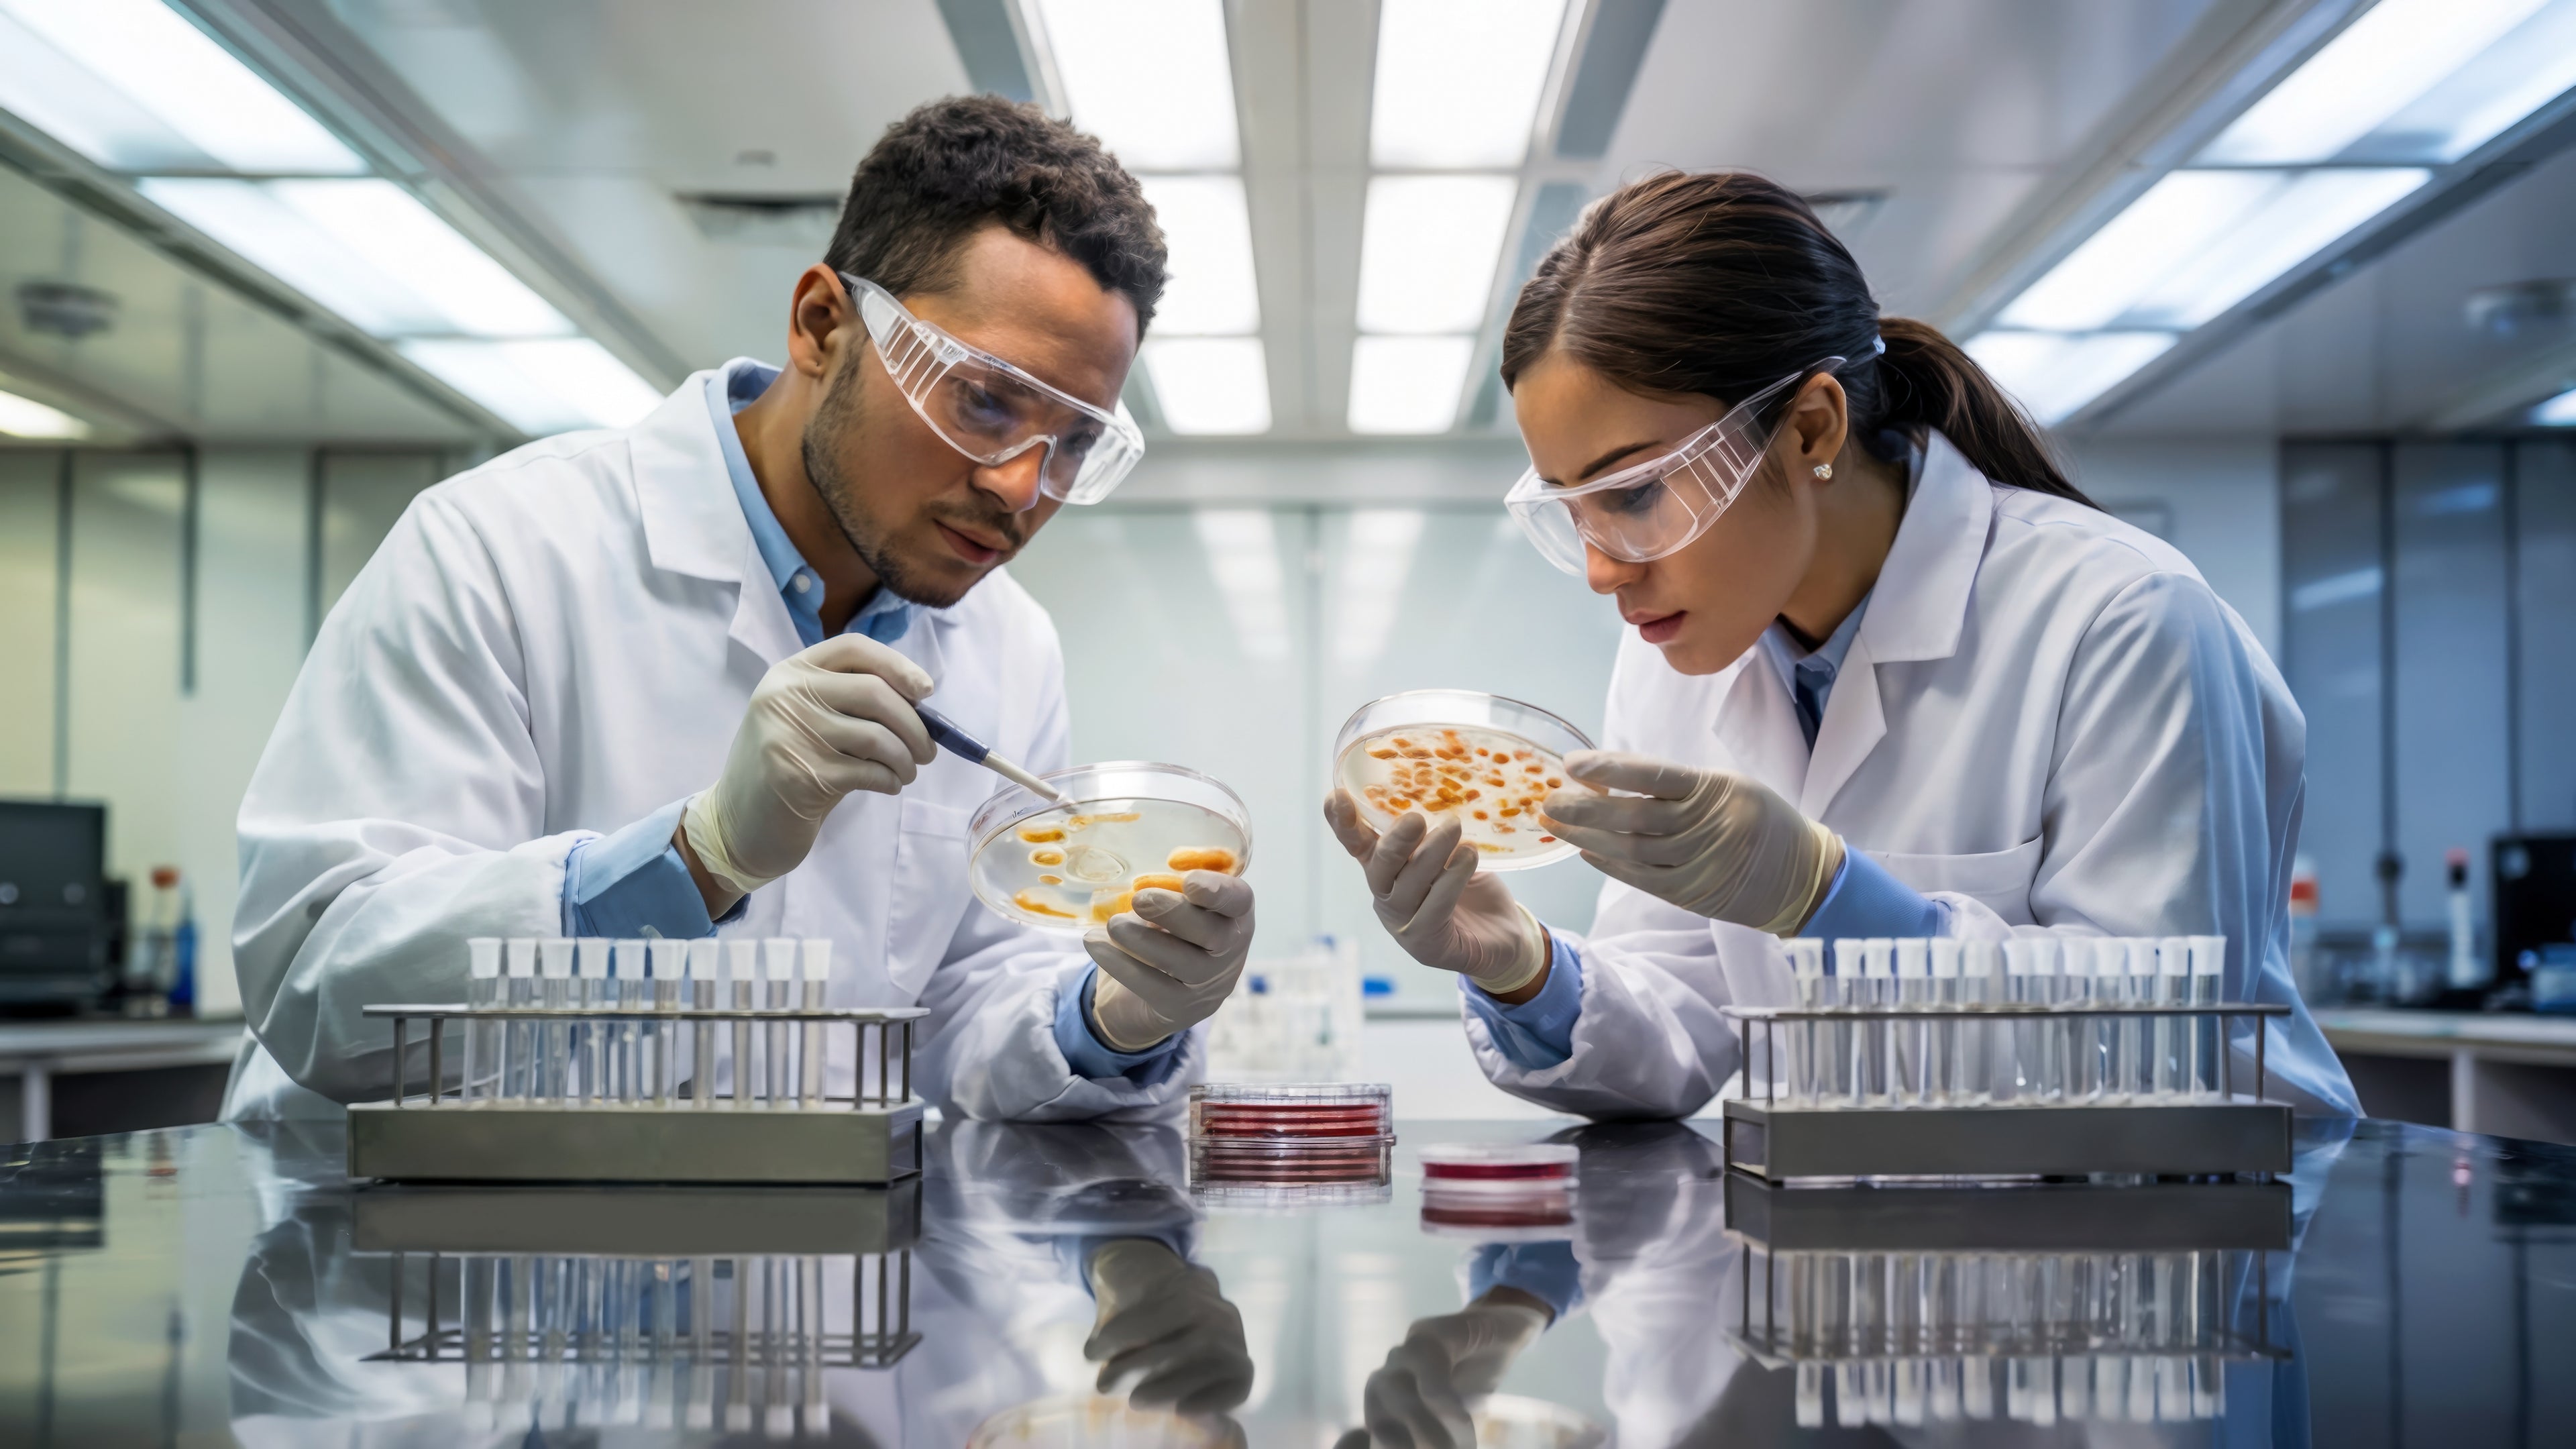

In Vitro Study: BasicBites helps maintain a healthy plaque pH, even after sugar exposure.

How BasicBites Works
BasicBites delivers arginine bicarbonate and calcium carbonate that activates your mouth's natural defense system:
Prebiotic Action: Feeding the Good Bacteria
Arginine nourishes beneficial bacteria already living on your tooth surfaces—including Streptococcus sanguinis, S. gordonii, S. parasanguinis, and other alkali-producing species. These bacteria possess the Arginine Deiminase System (ADS), specialized enzymes that metabolize arginine.
Postbiotic Action: Neutralizing Acid
When these bacteria metabolize arginine, they produce buffers that immediately neutralize plaque acids and maintain a healthier pH at the tooth surface.
Enhanced Remineralization
In this pH-balanced environment, calcium works more effectively to support natural enamel remineralization. The bicarbonate and carbonate provide additional buffering power, complementing arginine's natural protective system.
Microbial Balance
With regular use, our technology has been shown to support the beneficial, pH-raising bacteria while limiting conditions that favor acid-producing species like Streptococcus mutans—creating a healthier oral ecosystem.



